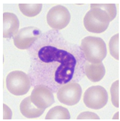
Applsci 13 05296 i001
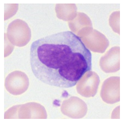
Applsci 13 05296 i005
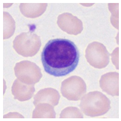
Applsci 13 05296 i006
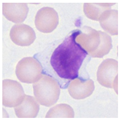
Applsci 13 05296 i007

Classifying Microscopic Images of Reactive Lymphocytosis Using Two-Step Tandem AI Models
Abstract
1. Introduction
2. Materials
2.1. Subjects for Supervised Training
2.2. Subjects for Clinical Assessment
2.3. Hardware and Software for Deep Learning
3. Methods
3.1. Preparation of Stained Smears
3.2. Microscopic Imaging
3.3. Labeling of Nucleated Blood Cell Images
3.4. Preparation of Datasets for Supervised Training
3.5. The Development of AI Models for the Identification of Reactive Lymphocytosis Cases
3.5.1. One-Step Model
3.5.2. Two-Step Model
- (1)
- The first model for normal nucleated blood cell classification
- (2)
- The second model for subcategory classification and verification
3.6. Clinical Assessment of AI Models for Reactive Lymphocyte Detection
4. Results
4.1. Validation Experiments of the AI Model
4.1.1. One-Step Model
4.1.2. Two-Step Model
- (1)
- The first model for normal nucleated blood cell classification
- (2)
- The second model for subcategory classification and verification
4.2. Clinical Assessments of the AI Model
4.2.1. Analysis of Healthy Cases
4.2.2. Analysis of Erythroblast Cases
4.2.3. Analysis of Reactive Lymphocytosis Cases
4.2.4. Comparison of Case Group Identification Performance in Clinical Assessments
5. Discussion
6. Conclusions
Author Contributions
Funding
Institutional Review Board Statement
Informed Consent Statement
Data Availability Statement
Acknowledgments
Conflicts of Interest
References
- Zahid, H.; Rizwana, K.; Shariq, B.; Ghulam, A. Artificial intelligence techniques for driving safety and vehicle crash prediction. Artif. Intell. Rev. 2016, 46, 351–387. [Google Scholar] [CrossRef]
- Konstantinos, G.L.; Patrizia, B.; Dimitrios, M.; Simon, P.; Dionysis, B. Machine Learning in Agriculture. Sensors 2018, 18, 2674. [Google Scholar] [CrossRef]
- Jianxing, H.; Sally, L.B.; Jie, X.; Jiming, X.; Xingtao, Z.; Kang, Z. The practical implementation of artificial intelligence technologies in medicine. Nat. Med. 2019, 25, 30–36. [Google Scholar] [CrossRef]
- Heang-Ping, C.; Ravi, K.S.; Lubomir, M.H.; Chuan, Z. Deep Learning in Medical Image Analysis. Adv. Exp. Med. Biol. 2020, 1213, 3–21. [Google Scholar] [CrossRef]
- Chabot-Richards, D.S.; George, T.I. White blood cell counts: Reference methodology. Clin. Lab. Med. 2015, 35, 11–24. [Google Scholar] [CrossRef]
- Edward, C.C.W. Hematology analyzers: Special considerations for pediatric patients. Clin. Lab. Med. 2015, 35, 165–181. [Google Scholar] [CrossRef]
- Gene, G.; Guldeep, U.; Jerald, G. Unreliable Automated Complete Blood Count Results: Causes, Recognition, and Resolution. Ann. Lab. Med. 2022, 42, 515–530. [Google Scholar] [CrossRef]
- Zandecki, M.; Genevieve, F.; Gerard, J.; Godon, A. Spurious counts and spurious results on haematology analysers: A review. Part II: White blood cells, red blood cells, haemoglobin, red cell indices and reticulocytes. Int. J. Hematol. 2007, 29, 21–41. [Google Scholar] [CrossRef]
- Chabot-Richards, D.S.; George, T.I. Leukocytosis. Int. J. Lab. Hematol. 2014, 36, 279–288. [Google Scholar] [CrossRef]
- Page, W.; Eric, S.W. Leukocytosis and Leukemia. Prim. Care 2016, 43, 575–587. [Google Scholar] [CrossRef]
- Amer, W.; Amitava, D. Complete Blood Count and Peripheral Smear Examination. In Hematology and Coagulation, 1st ed.; Elsevier: Amsterdam, The Netherlands, 2015; pp. 1–14. [Google Scholar] [CrossRef]
- Yapin, W.; Yiping, C. Human peripheral blood leukocyte classification method based on convolutional neural network and data augmentation. Med. Phys. 2020, 47, 142–151. [Google Scholar] [CrossRef]
- Qiwei, W.; Shusheng, B.; Minglei, S.; Yuliang, W.; Di, W.; Shaobao, Y. Deep learning approach to peripheral leukocyte recognition. PLoS ONE 2019, 14, e0218808. [Google Scholar] [CrossRef]
- Lei, J.; Chang, T.; Hua, Z. White blood cell classification via a discriminative region detection assisted feature aggregation network. Biomed. Opt. Express 2022, 13, 5246–5260. [Google Scholar] [CrossRef]
- Chen, Y.M.; Chou, F.I.; Ho, W.H.; Tsai, J.T. Classifying microscopic images as acute lymphoblastic leukemia by Resnet ensemble model and Taguchi method. BMC Bioinform. 2022, 22, 615. [Google Scholar] [CrossRef] [PubMed]
- Jawahar, M.; H, S.; L, J.A.; Gandomi, A.H. ALNett: A cluster layer deep convolutional neural network for acute lymphoblastic leukemia classification. Comput. Biol. Med. 2022, 148, 105894. [Google Scholar] [CrossRef] [PubMed]
- Abunadi, I.; Senan, E.M. Multi-Method Diagnosis of Blood Microscopic Sample for Early Detection of Acute Lymphoblastic Leukemia Based on Deep Learning and Hybrid Techniques. Sensors 2022, 22, 1629. [Google Scholar] [CrossRef] [PubMed]
- Musleh, S.; Islam, M.T.; Alam, M.T.; Househ, M.; Shah, Z.; Alam, T. ALLD: Acute Lymphoblastic Leukemia Detector. Stud. Health Technol. Inform. 2022, 289, 77–80. [Google Scholar] [CrossRef] [PubMed]
- Bigorra, L.; Larriba, I.; Gutiérrez-Gallego, R. A Physician-in-the-Loop Approach by Means of Machine Learning for the Diagnosis of Lymphocytosis in the Clinical Laboratory. Arch. Pathol. Lab. Med. 2022, 146, 1024–1031. [Google Scholar] [CrossRef]
- Sahasrabudhe, M.; Sujobert, P.; Zacharaki, E.I.; Maurin, E.; Grange, B.; Jallades, L.; Paragios, N.; Vakalopoulou, M. Deep Multi-Instance Learning Using Multi-Modal Data for Diagnosis of Lymphocytosis. IEEE J. Biomed. Health Inform. 2021, 25, 2125–2136. [Google Scholar] [CrossRef]
- Pałczyński, K.; Śmigiel, S.; Gackowska, M.; Ledziński, D.; Bujnowski, S.; Lutowski, Z. IoT Application of Transfer Learning in Hybrid Artificial Intelligence Systems for Acute Lymphoblastic Leukemia Classification. Sensors 2021, 21, 8025. [Google Scholar] [CrossRef]
- Rezayi, S.; Mohammadzadeh, N.; Bouraghi, H.; Saeedi, S.; Mohammadpour, A. Timely Diagnosis of Acute Lymphoblastic Leukemia Using Artificial Intelligence-Oriented Deep Learning Methods. Comput. Intell. Neurosci. 2021, 2021, 5478157. [Google Scholar] [CrossRef] [PubMed]
- Jiang, Z.; Dong, Z.; Wang, L.; Jiang, W. Method for Diagnosis of Acute Lymphoblastic Leukemia Based on ViT-CNN Ensemble Model. Comput. Intell. Neurosci. 2021, 2021, 7529893. [Google Scholar] [CrossRef] [PubMed]
- Mishra, S.; Shaw, K.; Mishra, D.; Patil, S.; Kotecha, K.; Kumar, S.; Bajaj, S. Improving the Accuracy of Ensemble Machine Learning Classification Models Using a Novel Bit-Fusion Algorithm for Healthcare AI Systems. Front. Public Health 2022, 10, 858282. [Google Scholar] [CrossRef] [PubMed]
- Claro, M.L.; Veras, R.M.S.; Santana, A.M.; Vogado, L.H.S.; Braz, J.G.; Medeiros, F.N.S.; Tavares, J.M.R.S. Assessing the impact of data augmentation and a combination of CNNs on leukemia classification. Inf. Sci. 2022, 609, 1010–1029. [Google Scholar] [CrossRef]
- Takuya, N.; Javier, A.; Fabien, C.; Akio, H.; Masato, I.; Kazunori, I.; Thomas, K.; Yoshiyuki, K.; Lukas, M.; Akira, N.; et al. Neural Network Libraries: A Deep Learning Framework Designed from Engineers’ Perspectives. arXiv 2021, arXiv:2102.06725. [Google Scholar]
- Kaiming, H.; Xiangyu, Z.; Shaoqing, R.; Jian, S. Deep Residual Learning for Image Recognition. arXiv 2015, arXiv:1512.03385. [Google Scholar]
- Tohyama, K. Present status and perspective of laboratory hematology in Japan: On the standardization of blood cell morphology including myelodysplasia. Int. J. Lab. Hematol. 2018, 40, 120–125. [Google Scholar] [CrossRef] [PubMed]
- Palmer, L.; Briggs, C.; McFadden, S.; Zini, G.; Burthem, J.; Rozenberg, G.; Proytcheva, M.; Machin, S.J. ICSH recommendations for the standardization of nomenclature and grading of peripheral blood cell morphological features. Int. J. Lab. Hematol. 2015, 37, 287–303. [Google Scholar] [CrossRef]
- Bigorra, L.; Merino, A.; Alférez, S.; Rodellar, J. Feature Analysis and Automatic Identification of Leukemic Lineage Blast Cells and Reactive Lymphoid Cells from Peripheral Blood Cell Images. J. Clin. Lab. Anal. 2017, 31, e22024. [Google Scholar] [CrossRef]
- Kim, D.H.; MacKinnon, T. Artificial intelligence in fracture detection: Transfer learning from deep convolutional neural networks. Clin. Radiol. 2018, 73, 439–445. [Google Scholar] [CrossRef]
- Lester, J.L.; Magda, E. A modified Papanicolaou Society of Cytopathology system for reporting respiratory cytology specimens: Implications for estimates of malignancy risk and diagnostic accuracy. Diagn. Cytopathol. 2021, 49, 1167–1172. [Google Scholar] [CrossRef]
- Nayar, R.; Wilbur, D.C. The Pap test and Bethesda 2014. Cancer Cytopathol. 2015, 123, 271–281. [Google Scholar] [CrossRef] [PubMed]
- Raza, S.H.; Elizabeth, B.F.; Ronald, N.A., 3rd; Matthew, R.; Martha, B.P. Risk of malignancy in the categories of the Papanicolaou Society of Cytopathology system for reporting pancreaticobiliary cytology. J. Am. Soc. Cytopathol. 2019, 8, 120–127. [Google Scholar] [CrossRef]
- Abir, W.H.; Uddin, M.F.; Khanam, F.R.; Tazin, T.; Khan, M.M.; Masud, M.; Aljahdali, S. Explainable AI in Diagnosing and Anticipating Leukemia Using Transfer Learning Method. Comput. Intell. Neurosci. 2022, 2022, 5140148. [Google Scholar] [CrossRef] [PubMed]
- Deshpande, N.M.; Gite, S.; Aluvalu, R. A review of microscopic analysis of blood cells for disease detection with AI perspective. PeerJ Comput. Sci. 2021, 7, e460. [Google Scholar] [CrossRef] [PubMed]
- Chen, H.; Liu, J.; Hua, C.; Feng, J.; Pang, B.; Cao, D.; Li, C. Accurate classification of white blood cells by coupling pre-trained ResNet and DenseNet with SCAM mechanism. BMC Bioinform. 2022, 23, 282. [Google Scholar] [CrossRef]
- Wang, Z.; Xiao, J.; Li, J.; Li, H.; Wang, L. WBC-AMNet: Automatic classification of WBC images using deep feature fusion network based on focalized attention mechanism. PLoS ONE 2022, 17, e0261848. [Google Scholar] [CrossRef]








| Author | Year | Application | Materials and Method | Algorithm | Results | Reference No |
|---|---|---|---|---|---|---|
| Chen, YM. et al., | 2022 | Diagnosis of acute lymphoblastic leukemia | Blood smear Microscopic image | Convolutional neural network | Resnet101-9 ensemble model achieved an accuracy of 85.11%. | [15] |
| Jawahar, M. et al., | 2022 | Diagnosis of acute lymphoblastic leukemia | Blood smear Microscopic image | Convolutional neural network | ALNett model yielded the highest classification accuracy of 91.13% | [16] |
| Abunadi, I. et al., | 2022 | Diagnosis of acute lymphoblastic leukemia | Blood smear Microscopic image | Artificial neural network, Feed forward neural network, Support vector machine | All the hybrid systems achieved promising results, with AlexNet + SVM achieving 100% accuracy, Goog-LeNet + SVM achieving 98.1% accuracy, and ResNet-18 + SVM achieving 100% accuracy. | [17] |
| Musleh, S. et al., | 2022 | Diagnosis of acute lymphoblastic leukemia | Blood smear Microscopic image | Multiple deep learning models | ResNet-based model performed the best with 98% accuracy. | [18] |
| Bigorra, L. et al., | 2022 | Diagnosis of lymphocytosis | Whole blood Flow cytometry | Decision trees, Random forests, Naive bayes classifier, k-nearest neighbor, Neural networks, Support vector machines | Diagnostic accuracy corresponded to 91%. | [19] |
| Sahasrabudhe, M. et al., | 2021 | Diagnosis of lymphocytosis | Blood smear Microscopic image | Multi-Instance Learning | Balanced accuracy of Multi-Instance Learning was 85.41%. | [20] |
| Pałczyński, K. et al., | 2021 | Acute lymphoblastic leukemia classification | Blood smear Microscopic image | Decision trees, Random forests, XGBoost, Convolutional Neural Network | The average accuracy was over 90%, reaching 97.4%. | [21] |
| Rezayi, S. et al., | 2021 | Diagnosis of acute lymphoblastic leukemia | Blood smear Microscopic image | Convolutional neural network | The validation accuracies of ResNet-50 and VGG-16 were 81.63% and 84.62%. | [22] |
| Morphological Feature | Neutrophil | Eosinophil | Basophil | Monocyte | Lymphocyte | Erythroblast (Poly or Ortho) | ||
|---|---|---|---|---|---|---|---|---|
| Rod-Shaped Nucleus | Segmental Nucleus | Small | Large | |||||
| Size | 12~15 μm | 12~15 μm | 13~15 μm | 10~16 μm | 12~15 μm | 9~12 μm | 12~16 μm | 10~15 μm |
| Nuclear |
|
|
|
|
|
|
|
|
| Cytoplasm |
|
|
|
|
|
|
|
|
| Intracytoplasmic granules |
|
|
|
|
|
|
|
|
| Typical morphology | ![]() | ![]() | ![]() | ![]() | ![]() | ![]() | ![]() | ![]() |
| Morphological Feature Downy’s Categorization | Atypical Lymphocyte | ||
|---|---|---|---|
| Type I (Monocyte-like) | Type II (Plasma Cell like) | Type III (Lymphoblast like) | |
| Size | 16 μm~ | 16 μm~ | 16 μm~ |
| Nuclear |
|
|
|
| Cytoplasm |
|
|
|
| Intracytoplasmic granules |
| ||
| Typical morphology | ![]() | ![]() | ![]() |
| Cell Category | Sub-Category | Dataset A | Dataset B | Dataset C | Dataset D |
|---|---|---|---|---|---|
| Neutrophil | (Band) | 769 | 769 | ||
| (Segment) | 836 | 836 | |||
| Eosino | 599 | 599 | |||
| Baso | 469 | 469 | |||
| Mono | 839 | 839 | 839 | ||
| Lymphocyte | (Lymph) | 921 | 1632 | 921 | 921 |
| (A-lymph) | 711 | 711 | 711 | ||
| EB | 621 | 621 | 621 | ||
| Total | 5765 | 5765 | 2253 | 2471 |
| Cell Category | Sub-Category | Healthy Cases | Erythroblast Cases | Reactive Lymphocytosis Cases |
|---|---|---|---|---|
| Neutrophil | (Band) | 9 | 185 | 68 |
| (Segment) | 1741 | 2229 | 964 | |
| Eosino | 48 | 65 | 44 | |
| Baso | 41 | 37 | 18 | |
| Mono | 143 | 505 | 730 | |
| Lymphocyte | (Lymph) | 1228 | 1040 | 2149 |
| (A-lymph) | 1 | 9 | 1118 | |
| EB | 1 | 1182 | 0 | |
| Total | 3212 | 5252 | 5091 |
| Optimizer | One-Step Model | Two-Step MODEL | ||
|---|---|---|---|---|
| First Model | Second Model 1 (For EB) | Second Model 2 (For Lymph) | ||
| AdaBound | 0.1094 | 0.0816 | 0.0357 | 0.0714 |
| AMSBound | 0.1085 | 0.0807 | 0.0334 | 0.0558 * |
| AdaGrad | 0.1006 | 0.0660 * | 0.0313 * | 0.0714 |
| AMSGrad | 0.0963 * | 0.0720 | 0.0402 | 0.0714 |
| Experts/AI | Neutrophil (Band/Segment) | Eosino | Baso | Mono | Lymph | A-Lymph | EB | Recall |
|---|---|---|---|---|---|---|---|---|
| Neutrophil (Band/Segment) | 1695 | 1 | 54 | 0 | 0 | 0 | 0 | 0.969 |
| Eosino | 0 | 48 | 0 | 0 | 0 | 0 | 0 | 1.000 |
| Baso | 0 | 0 | 41 | 0 | 0 | 0 | 0 | 1.000 |
| Mono | 0 | 0 | 0 | 141 | 2 | 0 | 0 | 0.986 |
| Lymph | 0 | 0 | 7 | 7 | 1195 | 1 | 18 | 0.973 |
| A-lymph | 0 | 0 | 0 | 0 | 0 | 1 | 0 | - |
| EB | 0 | 0 | 0 | 0 | 0 | 0 | 1 | - |
| Precision | 1.000 | 0.980 | 0.402 | 0.953 | 0.998 | - | - | |
| F-measure | 0.984 | 0.990 | 0.573 | 0.969 | 0.986 | - | - |
| Experts/AI | Neutrophil (Band/Segment) | Eosino | Baso | Mono | Lymph | A-Lymph | EB | Recall |
|---|---|---|---|---|---|---|---|---|
| Neutrophil (Band/Segment) | 1745 | 0 | 5 | 0 | 0 | 0 | 0 | 0.997 |
| Eosino | 0 | 48 | 0 | 0 | 0 | 0 | 0 | 1.000 |
| Baso | 0 | 0 | 41 | 0 | 0 | 0 | 0 | 1.000 |
| Mono | 0 | 0 | 0 | 143 | 0 | 0 | 0 | 1.000 |
| Lymph | 5 | 2 | 30 | 25 | 1158 | 4 | 4 | 0.943 |
| A-lymph | 0 | 0 | 0 | 0 | 0 | 1 | 0 | - |
| EB | 0 | 0 | 0 | 0 | 0 | 0 | 1 | - |
| Precision | 0.997 | 0.960 | 0.539 | 0.851 | 1.000 | - | - | |
| F-measure | 0.997 | 0.980 | 0.701 | 0.920 | 0.971 | - | - |
| Experts/AI | Neutrophil (Band/Segment) | Eosino | Baso | Mono | Lymph | A-Lymph | EB | Recall |
|---|---|---|---|---|---|---|---|---|
| Neutrophil (Band/Segment) | 2267 | 23 | 117 | 1 | 0 | 0 | 6 | 0.939 |
| Eosino | 0 | 65 | 0 | 0 | 0 | 0 | 0 | 1.000 |
| Baso | 0 | 0 | 37 | 0 | 0 | 0 | 0 | 1.000 |
| Mono | 24 | 4 | 7 | 410 | 46 | 14 | 0 | 0.812 |
| Lymph | 0 | 0 | 0 | 11 | 989 | 2 | 38 | 0.951 |
| A-lymph | 0 | 0 | 0 | 1 | 7 | 1 | 0 | - |
| EB | 0 | 0 | 0 | 0 | 0 | 0 | 1182 | 1.000 |
| Precision | 0.990 | 0.707 | 0.230 | 0.969 | 0.949 | - | 0.964 | |
| F-measure | 0.964 | 0.828 | 0.374 | 0.884 | 0.950 | - | 0.982 |
| Experts/AI | Neutrophil (Band/Segment) | Eosino | Baso | Mono | Lymph | A-Lymph | EB | Recall |
|---|---|---|---|---|---|---|---|---|
| Neutrophil (Band/Segment) | 2403 | 0 | 11 | 0 | 0 | 0 | 0 | 0.995 |
| Eosino | 0 | 65 | 0 | 0 | 0 | 0 | 0 | 1.000 |
| Baso | 0 | 0 | 37 | 0 | 0 | 0 | 0 | 1.000 |
| Mono | 15 | 0 | 5 | 462 | 11 | 12 | 0 | 0.915 |
| Lymph | 2 | 0 | 4 | 18 | 999 | 6 | 11 | 0.961 |
| A-lymph | 0 | 0 | 0 | 1 | 5 | 3 | 0 | - |
| EB | 1 | 0 | 3 | 0 | 3 | 0 | 1175 | 0.994 |
| Precision | 0.993 | 1.000 | 0.617 | 0.960 | 0.981 | - | 0.991 | |
| F-measure | 0.994 | 1.000 | 0.763 | 0.937 | 0.971 | - | 0.992 |
| Experts/AI | Neutrophil (Band/Segment) | Eosino | Baso | Mono | Lymph | A-Lymph | EB | Recall |
|---|---|---|---|---|---|---|---|---|
| Neutrophil (Band/Segment) | 985 | 1 | 46 | 0 | 0 | 0 | 0 | 0.954 |
| Eosino | 0 | 44 | 0 | 0 | 0 | 0 | 0 | 1.000 |
| Baso | 0 | 0 | 18 | 0 | 0 | 0 | 0 | 1.000 |
| Mono | 1 | 2 | 0 | 585 | 101 | 41 | 0 | 0.801 |
| Lymph | 1 | 0 | 1 | 49 | 2010 | 77 | 11 | 0.935 |
| A-lymph | 0 | 0 | 0 | 37 | 361 | 720 | 0 | 0.644 |
| EB | 0 | 0 | 0 | 0 | 0 | 0 | 0 | - |
| Precision | 0.998 | 0.936 | 0.277 | 0.872 | 0.813 | 0.859 | - | |
| F-measure | 0.976 | 0.967 | 0.434 | 0.835 | 0.870 | 0.736 | - |
| Experts/AI | Neutrophil (Band/Segment) | Eosino | Baso | Mono | Lymph | A-Lymph | EB | Recall |
|---|---|---|---|---|---|---|---|---|
| Neutrophil (Band/Segment) | 1028 | 0 | 2 | 2 | 0 | 0 | 0 | 0.996 |
| Eosino | 0 | 44 | 0 | 0 | 0 | 0 | 0 | 1.000 |
| Baso | 0 | 0 | 18 | 0 | 0 | 0 | 0 | 1.000 |
| Mono | 1 | 0 | 1 | 652 | 15 | 57 | 0 | 0.898 |
| Lymph | 2 | 0 | 7 | 142 | 1830 | 172 | 0 | 0.850 |
| A-lymph | 0 | 0 | 0 | 104 | 192 | 822 | 0 | 0.735 |
| EB | 0 | 0 | 0 | 0 | 0 | 0 | 0 | - |
| Precision | 0.997 | 1.000 | 0.643 | 0.724 | 0.898 | 0.782 | - | |
| F-measure | 0.997 | 1.000 | 0.783 | 0.802 | 0.874 | 0.758 | - |
| One-Step Model | AI | Total | Two-Step Model | AI | Total | ||||
|---|---|---|---|---|---|---|---|---|---|
| Erythroblast | Healthy | Erythroblast | Healthy | ||||||
| Experts | Erythroblast | 25 | 0 | 25 | Experts | Erythroblast | 25 | 0 | 25 |
| Healthy | 0 | 25 | 25 | Healthy | 0 | 25 | 25 | ||
| Total | 25 | 25 | 50 | Total | 25 | 25 | 50 | ||
| One-Step Model | AI | Total | Two-Step Model | AI | Total | ||||
|---|---|---|---|---|---|---|---|---|---|
| Reactive Lymphocytosis | Healthy | Reactive Lymphocytosis | Healthy | ||||||
| Experts | Reactive Lymphocytosis | 22 | 3 | 25 | Experts | Reactive Lymphocytosis | 24 | 1 | 25 |
| Healthy | 0 | 25 | 25 | Healthy | 0 | 25 | 25 | ||
| Total | 22 | 28 | 50 | Total | 24 | 26 | 50 | ||
Disclaimer/Publisher’s Note: The statements, opinions and data contained in all publications are solely those of the individual author(s) and contributor(s) and not of MDPI and/or the editor(s). MDPI and/or the editor(s) disclaim responsibility for any injury to people or property resulting from any ideas, methods, instructions or products referred to in the content. |
© 2023 by the authors. Licensee MDPI, Basel, Switzerland. This article is an open access article distributed under the terms and conditions of the Creative Commons Attribution (CC BY) license (https://creativecommons.org/licenses/by/4.0/).
Share and Cite
Nozaka, H.; Kushibiki, M.; Kamata, K.; Yamagata, K. Classifying Microscopic Images of Reactive Lymphocytosis Using Two-Step Tandem AI Models. Appl. Sci. 2023, 13, 5296. https://doi.org/10.3390/app13095296
Nozaka H, Kushibiki M, Kamata K, Yamagata K. Classifying Microscopic Images of Reactive Lymphocytosis Using Two-Step Tandem AI Models. Applied Sciences. 2023; 13(9):5296. https://doi.org/10.3390/app13095296
Chicago/Turabian StyleNozaka, Hiroyuki, Mihoko Kushibiki, Kosuke Kamata, and Kazufumi Yamagata. 2023. "Classifying Microscopic Images of Reactive Lymphocytosis Using Two-Step Tandem AI Models" Applied Sciences 13, no. 9: 5296. https://doi.org/10.3390/app13095296
APA StyleNozaka, H., Kushibiki, M., Kamata, K., & Yamagata, K. (2023). Classifying Microscopic Images of Reactive Lymphocytosis Using Two-Step Tandem AI Models. Applied Sciences, 13(9), 5296. https://doi.org/10.3390/app13095296